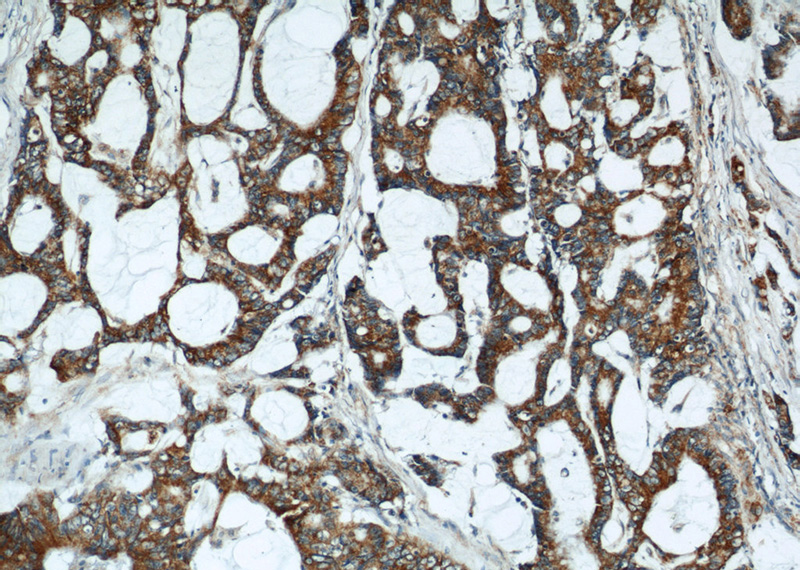
Immunohistochemical of paraffin-embedded human colon cancer using Catalog No:109785(CYCS antibody) at dilution of 1:50 (under 10x lens)
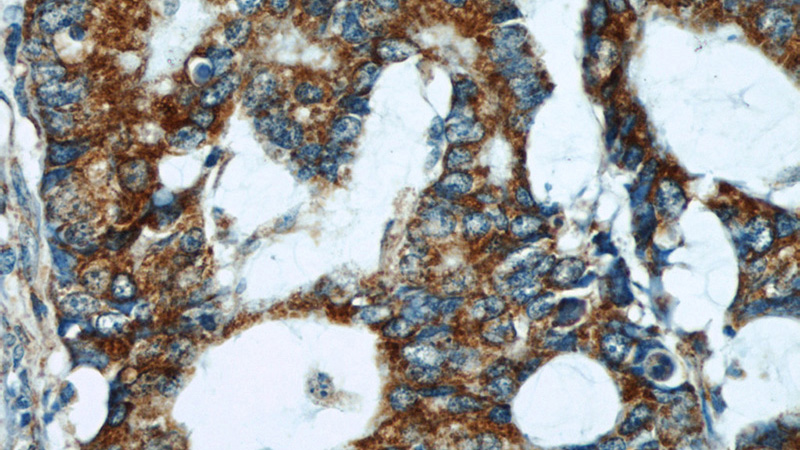
Immunohistochemical of paraffin-embedded human colon cancer using Catalog No:109785(CYCS antibody) at dilution of 1:50 (under 40x lens)

-
Product Name
Cytochrome c antibody
- Documents
-
Description
Cytochrome c Rabbit Polyclonal antibody. Positive WB detected in rat skeletal muscle tissue, MCF7 cells, mouse kidney tissue, mouse skeletal muscle tissue, NIH/3T3 cells, rat liver tissue. Positive IHC detected in human colon cancer tissue, human breast cancer tissue, human liver tissue. Observed molecular weight by Western-blot: 12-15 kDa
-
Tested applications
ELISA, IHC, WB
-
Species reactivity
Human, Mouse, Rat; other species not tested.
-
Alternative names
CYC antibody; CYCS antibody; CytOChrome c antibody; cytOChrome c antibody; somatic antibody; HCS antibody; THC4 antibody
-
Isotype
Rabbit IgG
-
Preparation
This antibody was obtained by immunization of Cyt℃hrome c recombinant protein (Accession Number: NM_018947). Purification method: Antigen affinity purified.
-
Clonality
Polyclonal
-
Formulation
PBS with 0.1% sodium azide and 50% glycerol pH 7.3.
-
Storage instructions
Store at -20℃. DO NOT ALIQUOT
-
Applications
Recommended Dilution:
WB: 1:200-1:2000
IHC: 1:20-1:400
-
Validations

rat skeletal muscle tissue were subjected to SDS PAGE followed by western blot with Catalog No:109785(CYCS antibody) at dilution of 1:800
Immunohistochemical of paraffin-embedded human colon cancer using Catalog No:109785(CYCS antibody) at dilution of 1:50 (under 10x lens)
Immunohistochemical of paraffin-embedded human colon cancer using Catalog No:109785(CYCS antibody) at dilution of 1:50 (under 40x lens)
-
Background
Cytochrome c is a 12-15 kDa electron transporting protein located in the inner mitochondrial membrane. As a part of respiratory chain, cytochrome c plays a critical role in the process of oxidative phosphorylation and ATP producing. Besides, cytochrome c also gets implicated in apoptosis process. Upon apoptotic stimulation, cytochrome c can be released from mitochondria into cytoplasm, which is required for caspase-3 activation and the occurrence of apoptosis.
-
References
- Gong K, Xie J, Yi H, Li W. CS055 (Chidamide/HBI-8000), a novel histone deacetylase inhibitor, induces G1 arrest, ROS-dependent apoptosis and differentiation in human leukaemia cells. The Biochemical journal. 443(3):735-46. 2012.
- Lei JC, Yu JQ, Yin Y, Liu YW, Zou GL. Alantolactone induces activation of apoptosis in human hepatoma cells. Food and chemical toxicology : an international journal published for the British Industrial Biological Research Association. 50(9):3313-9. 2012.
- Yu JQ, Bao W, Lei JC. Emodin regulates apoptotic pathway in human liver cancer cells. Phytotherapy research : PTR. 27(2):251-7. 2013.
- Liu G, Tian H, Huang YQ. Alterations of mitochondrial protein assembly and jasmonic acid biosynthesis pathway in Honglian (HL)-type cytoplasmic male sterility rice. The Journal of biological chemistry. 287(47):40051-60. 2012.
- Yin X, Yu B, Tang Z. Bifidobacterium infantis-mediated HSV-TK/GCV suicide gene therapy induces both extrinsic and intrinsic apoptosis in a rat model of bladder cancer. Cancer gene therapy. 20(2):77-81. 2013.
- Wei Y, Xu Y, Han X. Anti-cancer effects of dioscin on three kinds of human lung cancer cell lines through inducing DNA damage and activating mitochondrial signal pathway. Food and chemical toxicology : an international journal published for the British Industrial Biological Research Association. 59:118-28. 2013.
- Tu JB, Ma RZ, Dong Q. Induction of apoptosis in infantile hemangioma endothelial cells by propranolol. Experimental and therapeutic medicine. 6(2):574-578. 2013.
- Chen S, Li X, Lu D. SOX2 regulates apoptosis through MAP4K4-survivin signaling pathway in human lung cancer cells. Carcinogenesis. 35(3):613-23. 2014.
Related Products / Services
Please note: All products are "FOR RESEARCH USE ONLY AND ARE NOT INTENDED FOR DIAGNOSTIC OR THERAPEUTIC USE"
